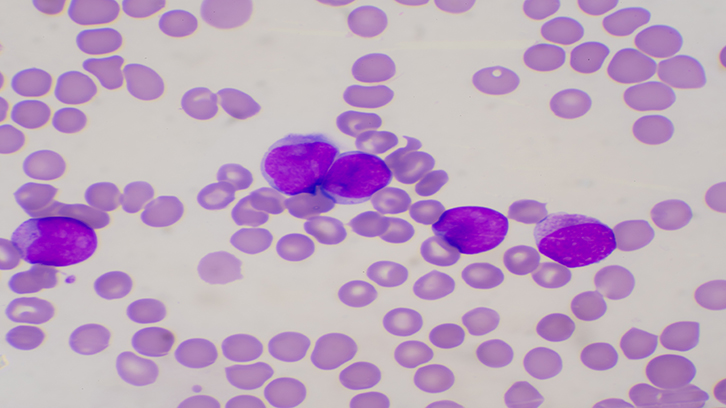
leucèmia

Quins elements i característiques han de tenir els boscos per influenciar la salut humana?
Malgrat el creixent interès de la comunitat científica i de la societat envers el potencial dels boscos com a font de salut humana, la literatura científica existent no permet establir...